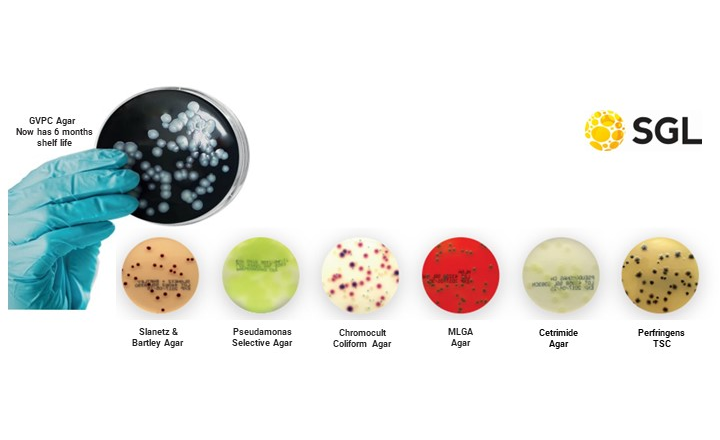
Discover High-Quality Pre-Poured Culture Media For Water Testing
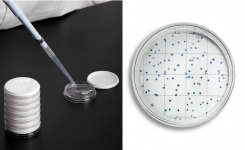
EasyDisc Fast Easy HPC in Water

- Listed as ISO Standard 7899-3, Water Quality - Enumeration of Intestinal Enterococci-Part 3: Most Probable Number Method
- More accurate and specific compared to ISO 7899-2.
- Confirmed results in 24 hours.
- Same easy-to-use platform as the Colilert-18 Test.
- Specified in the SCA Drinking Water 'Blue Book', The microbiology of Drinking Water Part 5.
- AFNOR Validation IDX 33/03-10/13 Enumeration of Intestinal Enterococci.
The IDEXX Enterolert™-DW test is an easy, trusted, and reliable method for enumerating enterococci in both drinking water and fresh and marine bathing waters. During its development, extensive studies were conducted on enterococci stressed by chlorine to mimic the impact of water treatment, resulting in a simplified testing method for utilities and laboratories that delivers fast, accurate results in just 24 hours.
The liquid culture method uses a defined substrate technology (DST) nutrient indicator to enumerate enterococci. It utilises ortho-nitrophenyl-β-D-glucoside as a nutrient indicator with a specifically designed blue background colour in its formulation. As a result, contamination by enterococci changes the sample colour from blue to green, removing subjectivity from interpreting results. When coupled with the IDEXX Quanti-Tray™, the Enterolert-DW test provides quantitative, confirmed results in 24 hours. The method requires no preparation steps, allowing samples to be processed in as little as 1 minute by simply adding the pre-weighed reagent to the water sample. The liquid enrichment process optimises recovery and delivers confirmed results – without the need for additional confirmation steps.
Enterolert-DW is now published as ISO standard 7899-3:2025 for the rapid enumeration of intestinal enterococci in drinking water and fresh and marine bathing water, having previously been shown by numerous independent studies, and in accordance with ISO 13843, to be more sensitive and specific when compared to ISO 7899-2.
Alongside the ISO recognition, Enterolert-DW is included in the UK Standing Committee of Analysts’ publication, “The Microbiology of Drinking Water Part 5: Methods for the Isolation and enumeration of enterococci”. It is also validated by AFNOR as IDX 33/03-10/13 - Enumeration of Intestinal Enterococci.
Enterolert-DW uses similar technology to the IDEXX Colilert™-18 method, which detects coliforms and E. coli in drinking water and fresh and marine bathing water. Colilert-18’s speed to confirmed results, in just 18 hours, offers many advantages over traditional membrane filtration methods, and in 2012, the Colilert-18/Quanti-Tray™ method became the ISO standard 9308-2. Combining the Colilert-18 and Enterolert-DW tests allows laboratories to standardise DST test methodologies, affording many benefits to workflow, training, the creation of standard operating procedures, and overall efficiency.
To learn more about Enterolert-DW click here or use the "Request Information" button below.